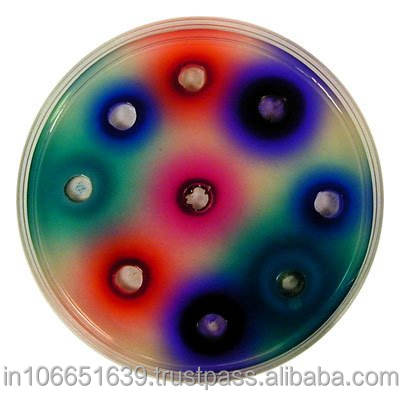

Atributos
6473-13-8CAS No.
Maharashtra, IndiaLugar del origen
Tinte directoTipo
Tintes de cuero, Tintes de papel, Materias colorantes textilesAplicación
MEGHA INTRNATIONALMarca
0EINECS No.
MF:0
Otros Nombres:NA
Número de Modelo:DYES
Detalles del embalaje:25 KGS PLASTIC DRUMS/ BAGS/ CARTONS WITH DOUBLE POLY BAG INSIDE, OF EXCELLENT QUALITY
Puerto de despacho:MUMBAI
Unidades de venta:Artículo individual
Capacidad de suministro:1000 kilogramos por Month












